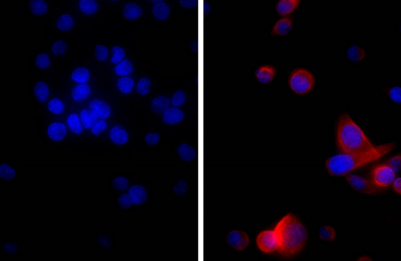
1012-01.png

PRODUCT CENTER
特色產(chǎn)品當(dāng)前位置:首頁 > 特色產(chǎn)品
純化的山羊F(ab')2抗小鼠Ig抗體,對(duì)人類蛋白的反應(yīng)性極低,可用于酶聯(lián)免疫吸附試驗(yàn)(ELISA)、流式細(xì)胞術(shù)、免疫細(xì)胞化學(xué)、西方印跡、酶聯(lián)斑點(diǎn)試驗(yàn)(ELISpot)和刺激試驗(yàn)。
作為SouthernBiotech在中國(guó)的區(qū)域總代理,艾美捷科技強(qiáng)烈推薦SouthernBiotech熱銷產(chǎn)品山羊F(ab')2抗小鼠Ig,人吸附-未標(biāo)記。產(chǎn)品僅用于科研,不可用于臨床診斷。
| 產(chǎn)品名稱 | 貨號(hào) | 詳情 |
山羊F(ab')2抗小鼠Ig,人吸附-未標(biāo)記 | 1012-01 | 查看 |
山羊F(ab')2抗小鼠Ig,人吸附-未標(biāo)記:
同種型:山羊F(ab')?IgG
同種型對(duì)照:山羊F(ab')?IgG-UNLB
特異性:與小鼠IgG1、IgG2a、IgG2b、IgG2c、IgG3、IgM和IgA的重鏈和輕鏈發(fā)生反應(yīng)
來源:山羊抗小鼠Ig,人吸附(SB產(chǎn)品編號(hào)1010)的胃蛋白酶消化產(chǎn)物
交叉吸附:人免疫球蛋白和混合血清;可能與其他物種的免疫球蛋白發(fā)生反應(yīng)
偶聯(lián)物:UNLB(未偶聯(lián))
緩沖液配方:硼酸鹽緩沖生理鹽水,pH 8.2
克隆性:多克隆
濃度:0.5 mg/mL
體積:1.0 mL
推薦儲(chǔ)存條件:2-8°C
應(yīng)用
質(zhì)量檢測(cè)的相關(guān)格式應(yīng)用包括——
酶聯(lián)免疫吸附試驗(yàn)(ELISA)1-6
流式細(xì)胞術(shù)8-21
其他參考的相關(guān)格式應(yīng)用包括——
酶聯(lián)斑點(diǎn)試驗(yàn)
免疫細(xì)胞化學(xué)
西方印跡
刺激
產(chǎn)品圖片:
人胰腺癌細(xì)胞系MIA PaCa-2用小鼠抗細(xì)胞角蛋白18-UNLB(SB產(chǎn)品編號(hào)10085-01;右)染色,隨后用山羊F(ab')?抗小鼠Ig,人吸附-AF555(SB產(chǎn)品編號(hào)1012-32)和DAPI染色。
文獻(xiàn)參考:
1. Gerth AJ, Lin L, Peng SL. T-bet regulates T-independent IgG2a class switching. Int Immunol. 2003;15:937-44. (ELISA)
2. Oble DA, Collett E, Hsieh M, Ambj?rn M, Law J, Dutz J, et al. A novel T cell receptor transgenic animal model of seborrheic dermatitis-like skin disease. J Invest Dermatol. 2005;124:151-9. (ELISA)
3. Kang T, Oh G, Scandella E, Bolinger B, Ludewig B, Kovalenko A, et al. Mutation of a self-processing site in caspase-8 compromises its apoptotic but not its nonapoptotic functions in bacterial artificial chromosome-transgenic mice. J Immunol. 2008;181:2522-32. (ELISA)
SouthernBiotech(SBA)公司建于1982年,致力于為免疫研究的科學(xué)家提供各種親和純化的多克隆和單克隆二抗和其它特異性抗體,其中包括:熒光素和酶標(biāo)記物,低內(nèi)毒素/不含疊氮化物制劑,F(xiàn)(ab)和F(ab’)299片段化抗體,此外還有純化的免疫球蛋白、血清以及細(xì)胞外基質(zhì)蛋白等產(chǎn)品。作為SouthernBiotech在中國(guó)的區(qū)域總代理,艾美捷科技有限公司將為中國(guó)客戶提供全面的SouthernBiotech產(chǎn)品以及客戶訂制化服務(wù)。


微信掃碼在線客服